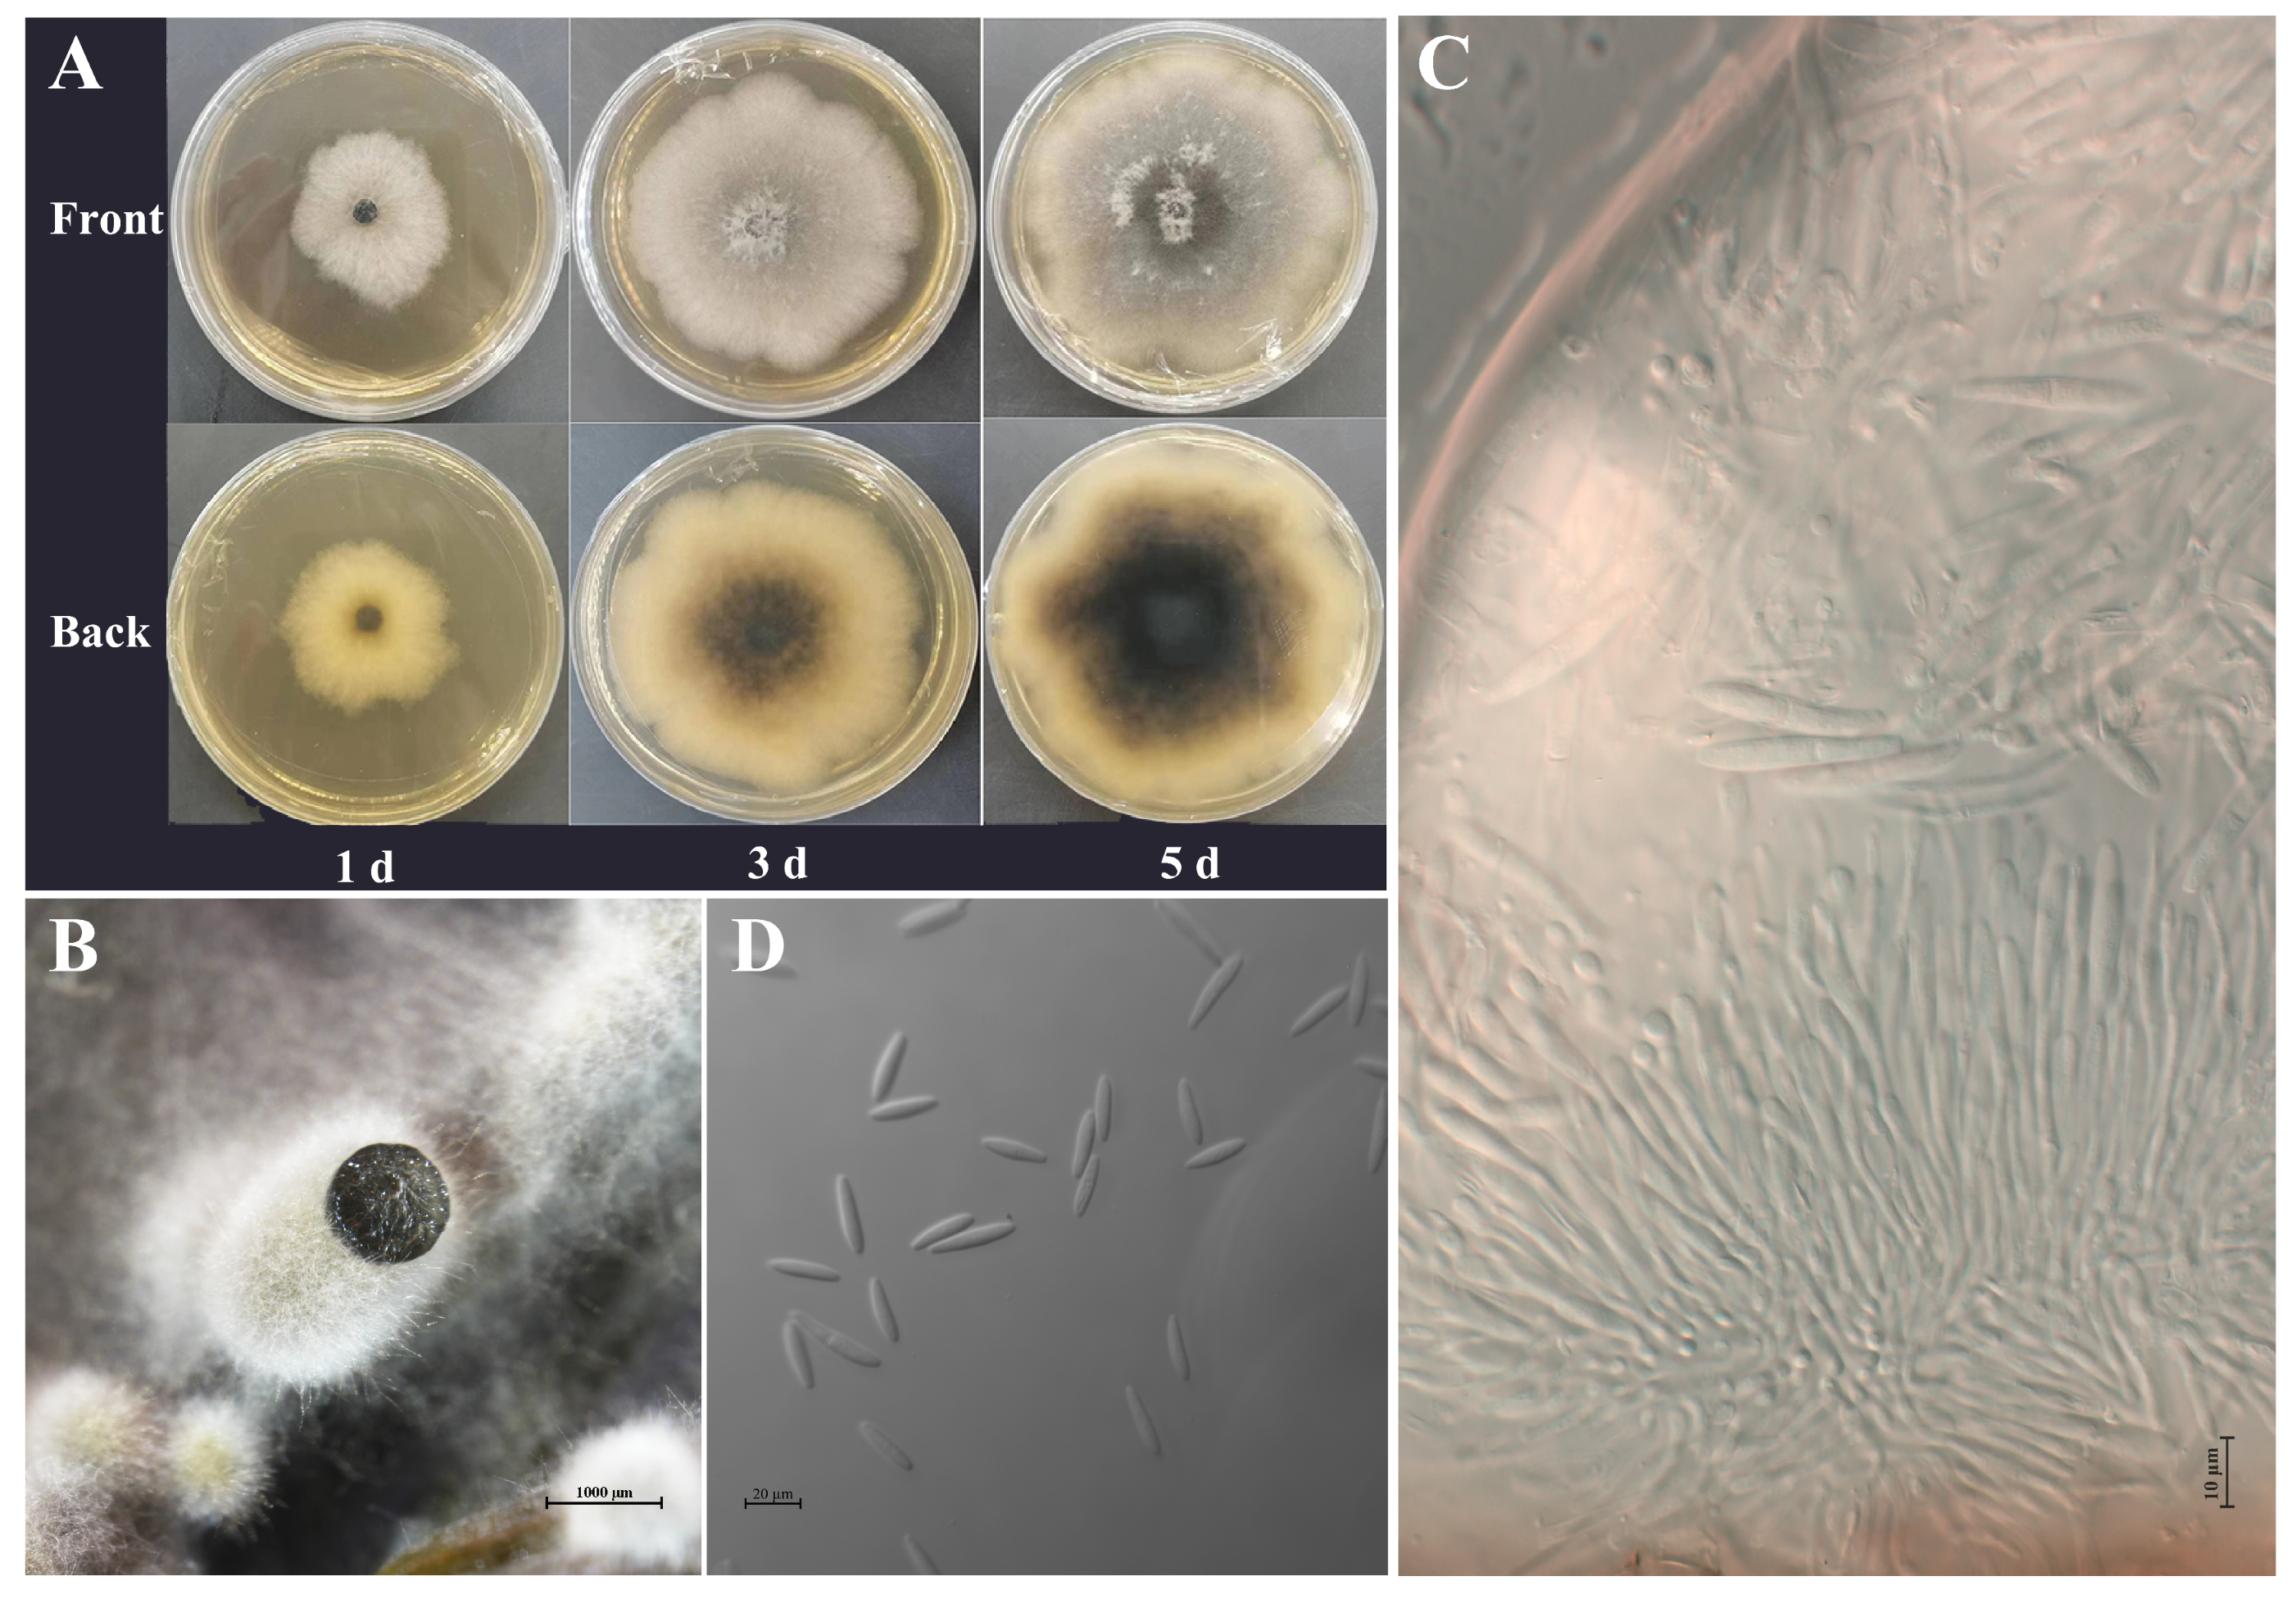
Plants 14 01393 g004

Identification and Chemical Control of Stem Canker Pathogen of Idesia polycarpa
Abstract
1. Introduction
2. Results
2.1. Symptoms of I. polycarpa Canker
2.2. Isolation of Pathogen and Determination of Pathogenicity
2.3. Morphological and Cultural Characteristics
2.4. Molecular Identification and Phylogenetic Analyses
2.5. Biological Characteristics
2.6. Screening of In Vitro Fungicides
2.7. Validation of Field Efficacy
3. Discussion
4. Materials and Methods
4.1. Investigation of Field Diseases
4.2. Pathogen Collection and Isolation
4.3. Pathogenicity Testing
4.4. Morphological and Cultural Characterization
4.5. Molecular Identification
4.6. Phylogenetic Analysis
4.7. Research on Biological Characteristics
4.8. In Vitro Fungicide Screening
4.9. Methods for Field Efficacy Verification
| Disease Rate | Representative Number | Grading Standard |
|---|---|---|
| I | 0 | No lesions |
| II | 1 | 1 to 10 spots on the main stem |
| III | 2 | The main stem has more than 10 spots and the width of the largest spot is less than 1/4 of the circumference of the tree. |
| IV | 3 | The main stem has more than 10 spots and the width of the largest spot is up to 1/4 but not more than 1/2 of the circumference of the tree. |
| V | 4 | The stem or branches are covered with disease scars, the maximum width of the spot is more than 1/2 the circumference of the tree, the branches and stems are crippled and the tree is weakened or even dead. |
4.10. Statistical Analysis
5. Conclusions
Supplementary Materials
Author Contributions
Funding
Data Availability Statement
Conflicts of Interest
References
- López-López, Á.; Allende-Molar, R.; Correia, K.C.; Tovar-Pedraza, J.M.; Márquez-Zequera, I.; García-Estrada, R.S. First report of stem canker of Tomato caused by Fusarium striatum in Mexico. Plant Dis. 2021, 105, 497. [Google Scholar] [CrossRef]
- Kovač, M.; Diminić, D.; Orlović, S.; Zlatković, M. Botryosphaeria dothidea and Neofusicoccum yunnanense causing canker and die-back of Sequoiadendron giganteum in Croatia. Forests 2021, 12, 695. [Google Scholar] [CrossRef]
- Hernández, D.; García-Pérez, O.; Perera, S.; González-Carracedo, M.A.; Rodríguez-Pérez, A.; Siverio, F. Fungal pathogens associated with aerial symptoms of avocado (Persea americana Mill.) in Tenerife (Canary Islands, Spain) focused on species of the family Botryosphaeriaceae. Microorganisms 2023, 11, 585. [Google Scholar] [CrossRef] [PubMed]
- Kenfaoui, J.; Lahlali, R.; Mennani, M.; Radouane, N.; Goura, K.; El Hamss, H.; El Ghadraoui, L.; Fontaine, F.; Tahiri, A.; Barka, E.A.; et al. Botryosphaeria dieback (Lasiodiplodia viticola): An imminent emerging threat to the Moroccan vineyards. Plants 2022, 11, 2167. [Google Scholar] [CrossRef] [PubMed]
- Houston, D.R.; Valentine, H.T. Beech bark disease: The temporal pattern of cankering in aftermath forests of Maine. Can. J. For. Res. 1988, 18, 38–42. [Google Scholar] [CrossRef]
- Ruess, R.W.; Winton, L.M.; Adams, G.C. Correction: Widespread mortality of trembling aspen (Populus tremuloides) throughout interior Alaskan boreal forests resulting from a novel canker disease. PLoS ONE 2021, 16, e0253996. [Google Scholar] [CrossRef]
- Chen, W.Y.; Jiang, N.; Fan, X.L.; Guo, H.L.; Tian, C.M. Preliminary identification of pathogenic fungal groups from Pinus armandii canker in Gansu Province. J. Northwest For. Univ. 2020, 35, 147–152. [Google Scholar]
- Lv, Q.; Zhang, Y.F.; Lin, R.Z.; Wang, H.M. Occurrence status of main forestry invasive species in China and their research trends. Plant Prot. 2022, 48, 21–38. [Google Scholar]
- Wang, H.; Rana, S.; Li, Z.; Xu, G.; Wang, Y.; Cai, Q.; Li, S.; Sun, J.; Liu, Z. Morphological and anatomical changes during floral bud development of the trioecious Idesia polycarpa Maxim. Braz. J. Bot. 2022, 45, 679–688. [Google Scholar] [CrossRef]
- Tian, X.X.; Fang, X.Z.; Du, M.H. Nutritional qualities and antioxidant properties of Idesia polycarpa Maxim. pulp oil and seed oil. J. Chin. Cereals Oils Assoc. 2020, 35, 91–95. [Google Scholar]
- Xiang, X.; Wen, L.; Wang, Z.; Yang, G.; Mao, J.; An, X.; Kan, J. A comprehensive study on physicochemical properties, bioactive compounds, and emulsified lipid digestion characteristics of Idesia polycarpa var. vestita Diels fruits oil. Food Chem. 2023, 404, 134634. [Google Scholar] [CrossRef] [PubMed]
- Zhou, D.; Zhou, X.; Shi, Q.; Pan, J.; Zhan, H.; Ge, F. High-pressure supercritical carbon dioxide extraction of Idesia polycarpa oil: Evaluation the influence of process parameters on the extraction yield and oil quality. Ind. Crops Prod. 2022, 188, 115586. [Google Scholar] [CrossRef]
- Ai, Q.; Ai, J.; Wang, L. Oil grape (Idesia polycarpa) is included in the general food management by the state. China For. Ind. 2020, 10, 40–41. [Google Scholar]
- Liu, Y. Analysis on the development and market prospect of oil grape (Idesia polycarpa) industry. China For. Ind. 2022, 2, 10–18. [Google Scholar]
- Zhou, J.; Luo, J.X.; Yu, Y.H.; Liu, F.R.; Huang, S.H.; He, H.G. Major disease types of Idesia polycarpa in Sichuan Province and its prevention and control suggestions. J. China West Norm. Univ. 2023, 44, 237–243. [Google Scholar]
- Zhu, Z.Y. Propagation Technology and Development and Utilization of Idesia polycarpa; Science Press: Beijing, China, 2010; pp. 206–222. [Google Scholar]
- Zheng, X.R.; Zhang, M.J.; Shang, X.L.; Fang, S.Z.; Chen, F.M. Stem canker on Cyclocarya paliurus is caused by Botryosphaeria dothidea. Plant Dis. 2020, 104, 1032–1040. [Google Scholar] [CrossRef]
- He, Y.; Qi, Z.; Li, S.; Zhu, H.; Hong, N.; Wang, G.; Wang, L. Molecular characterization of a new fusarivirus infecting Botryosphaeria dothidea, the causal agent of pear ring rot disease. Arch. Virol. 2022, 167, 1893–1897. [Google Scholar] [CrossRef]
- Zhang, Q.; Zhang, Y.; Shi, H.; Huo, Y. Botryosphaeria dothidea causing leaf blight of Photinia serrulata in China. Crop Prot. 2023, 174, 106412. [Google Scholar] [CrossRef]
- Dong, X.L.; Cheng, Z.Z.; Leng, W.F.; Li, B.H.; Xu, X.M.; Lian, S.; Wang, C.X. Progression of symptoms caused by Botryosphaeria dothidea on apple branches. Phytopathology 2021, 111, 1551–1559. [Google Scholar] [CrossRef]
- Ono, Y.; Chatasiri, S.; Tanaka, E. Ochropsora staphyleae, a new rust pathogen of Japanese bladdernut, found in central Japan. Mycoscience 2020, 61, 62–64. [Google Scholar] [CrossRef]
- Romero-Cuadrado, L.; López-Herrera, C.J.; Aguado, A.; Capote, N. Duplex real-time PCR assays for the simultaneous detection and quantification of Botryosphaeriaceae species Causing canker diseases in woody crops. Plants 2023, 12, 2205. [Google Scholar] [CrossRef] [PubMed]
- Sohrabi, M.; Mohammadi, H.; León, M.; Armengol, J.; Banihashemi, Z. Fungal pathogens associated with branch and trunk cankers of nut crops in Iran. Eur. J. Plant Pathol. 2020, 157, 327–351. [Google Scholar] [CrossRef]
- Gramaje, D.; Agustí-Brisach, C.; Pérez-Sierra, A.; Moralejo, E.; Olmo, D.; Mostert, L.; Damm, U.; Armengol, J. Fungal trunk pathogens associated with wood decay of almond trees on Mallorca (Spain). Persoonia Mol. Phylogeny Evol. Fungi 2012, 28, 1–13. [Google Scholar] [CrossRef] [PubMed]
- Gusella, G.; Giambra, S.; Conigliaro, G.; Burruano, S.; Polizzi, G. Botryosphaeriaceae species causing canker and dieback of English walnut (Juglans regia) in Italy. For. Pathol. 2020, 51, e12661. [Google Scholar] [CrossRef]
- Feng, X.; Lu, L.; Jia, Y.; Yan, X.; Zhongzhu, P.; Wang, G.; Qiu, C.; Wu, H. First report of trunk canker caused by Botryosphaeria dothidea on Cinnamomum camphora in China. Plant Dis. 2023, 107, 4030. [Google Scholar] [CrossRef]
- Wang, Y.; Chen, J.; Lan, X.X.; Ren, M.; Zhang, B. First report of shoot and leaf blight caused by Botryosphaeria dothidea on Taxus × media in Sichuan Province, China. Plant Dis. 2023, 107, 2852. [Google Scholar] [CrossRef]
- Fiorenza, A.; Aiello, D.; Costanzo, M.B.; Gusella, G.; Polizzi, G. A new disease for europe of Ficus microcarpa caused by Botryosphaeriaceae species. Plants 2022, 11, 727. [Google Scholar] [CrossRef]
- Zhuang, C.J.; Wang, Q.W.; Wu, Q.Q.; Qiu, Z.L.; Xu, B.C.; Zhang, C.Q. Diversity of Botryosphaeriaceae species associated with Chinese hickory tree (Carya cathayensis) trunk cankers. Plant Dis. 2021, 105, 3869–3879. [Google Scholar] [CrossRef]
- Tian, Y.; Zhao, Y.; Sun, T.; Wang, L.; Liu, J.; Ma, X.; Hu, B. Identification and characterization of Phomopsis amygdali and Botryosphaeria dothidea associated with peach shoot blight in Yangshan, China. Plant Dis. 2018, 102, 2511–2518. [Google Scholar] [CrossRef]
- Xing, J.; Li, P.; Zhang, Y.; Li, J.; Liu, Y.; Lachenbruch, B.; Su, X.; Zhao, J. Fungal pathogens of canker disease trigger canopy dieback in poplar saplings by inducing functional failure of the phloem and cambium and carbon starvation in the xylem. Physiol. Mol. Plant Pathol. 2020, 112, 101523. [Google Scholar] [CrossRef]
- Leal, C.; Trotel-Aziz, P.; Gramaje, D.; Armengol, J.; Fontaine, F. Exploring some factors conditioning the expression of Botryosphaeria dieback in grapevine for an integrated management of the disease. Phytopathology 2023, 114, 21–34. [Google Scholar] [CrossRef] [PubMed]
- Slippers, B.; Wingfield, M.J. Botryosphaeriaceae as endophytes and latent pathogens of woody plants: Diversity, ecology and impact. Fungal Biol. Rev. 2007, 21, 90–106. [Google Scholar] [CrossRef]
- Ntahimpera, N.; Driever, G.F.; Felts, D.; Morgan, D.P.; Michailides, T.J. Dynamics and pattern of latent infection caused by Botryosphaeria dothidea on Pistachio Buds. Plant Dis. 2002, 86, 282–287. [Google Scholar] [CrossRef] [PubMed]
- López-Moral, A.; Lovera, M.; Raya, M.D.; Cortés-Cosano, N.; Arquero, O.; Trapero, A.; Agustí-Brisach, C. Etiology of branch dieback and shoot blight of English walnut caused by Botryosphaeriaceae and Diaporthe species in southern Spain. Plant Dis. 2020, 104, 533–550. [Google Scholar] [CrossRef]
- Rezgui, A.; Ghnaya-Chakroun, A.B.; Vallance, J.; Bruez, E.; Hajlaoui, M.R.; Sadfi-Zouaoui, N.; Rey, P. Endophytic bacteria with antagonistic traits inhabit the wood tissues of grapevines from Tunisian vineyards. Biol. Control 2016, 99, 28–37. [Google Scholar] [CrossRef]
- Chen, W.; Xie, F.; Tian, C.; Li, F.; Chou, G. Identification and characterization of Neocosmospora silvicola causing canker disease on Pinus armandii in China. Plant Dis. 2023, 107, 3026–3036. [Google Scholar] [CrossRef]
- Li, Y.L.; Zhou, Z.; Yuan, C.Y.; Duan, P.L. Biological characteristics of the leaf spot lesions of Osmanthus fragrans and its resticide sensitivity. North. Hortic. 2014, 19, 117–120. [Google Scholar]
- Zhang, Q.; Li, Y.; Yang, P.; Zhang, J.H.; Ma, Z.H.; Zhang, L.Z. Biological characteristics of Botryosphaeria dothoidea from sweet cherry. Sci. Technol. Food Ind. 2020, 41, 101–106. [Google Scholar]
- Huang, Y.H.; Ning, P.; Huang, Y.G.; Ou, S.S.; Zhang, Y.X.; Tan, C.N.; Meng, C. Identification and biological characterization of stem rot pathogens from passion fruit. Southwest China J. Agric. Sci. 2022, 35, 105–112. [Google Scholar]
- Sun, J.E.; Meng, C.-R.; Phillips, A.J.L.; Wang, Y. Two new Botryosphaeria (Botryosphaeriales, Botryosphaeriaceae) species in China. MycoKeys 2022, 94, 1–16. [Google Scholar] [CrossRef]
- Li, T.; Li, N.; Lei, Z.; Zhang, C. Sensitivity and resistance risk of Botryosphaeria dothidea causing Chinese hickory trunk canker to fludioxonil. Pestic. Biochem. Physiol. 2023, 194, 105500. [Google Scholar] [CrossRef] [PubMed]
- Manetti, G.; Brunetti, A.; Lumia, V.; Sciarroni, L.; Marangi, P.; Cristella, N.; Faggioli, F.; Reverberi, M.; Scortichini, M.; Pilotti, M. Identification and characterization of Neofusicoccum stellenboschiana in branch and twig dieback-affected Olea europaea trees in Italy and comparative pathogenicity with N. mediterraneum. J. Fungi 2023, 9, 292. [Google Scholar] [CrossRef] [PubMed]
- Geng, X.; Liu, Y.; Li, J.; Li, Z.; Shu, J.; Wu, G. Identification and characterization of Nectria pseudotrichia associated with camellia canker disease in China. Forests 2022, 13, 29. [Google Scholar] [CrossRef]
- Dobry, E.; Rutter, M.A.; Campbell, M.A. The fungal pathogen Gnomoniopsis castaneae induces damaging cankers in multiple domestic Fagaceae Species. Phytopathology 2023, 113, 1817–1821. [Google Scholar] [CrossRef]
- Feng, H.; Wang, C.; Yang, H.; Tang, L.; Han, P.-L.; Liang, J.; Huang, L. Apple valsa canker: Insights into pathogenesis and disease control. Phytopathol. Res. 2023, 5, 45. [Google Scholar] [CrossRef]
- Tudela, M.A.A.; Lutz, M.C.; Giménez, G.N.; Del Brío, D.; Di Masi, S.N.; Pose, G.N.; Molina, J.P.E. Efficacy of fungicides against brown spot of pear in Argentina. Crop Prot. 2023, 174, 106425. [Google Scholar] [CrossRef]
- Li, W.; Hu, M.; Xue, Y.; Li, Z.; Zhang, Y.; Zheng, D.; Lu, G.; Wang, J.; Zhou, J. Five fungal pathogens are responsible for bayberry twig blight and fungicides were screened for disease control. Microorganisms 2020, 8, 689. [Google Scholar] [CrossRef]
- Denman, S.; Crous, P.W.; Sadie, A.; Wingfield, M.J. Evaluation of fungicides for the control of Botryosphaeria protearum on Protea magnifica in the Western Cape Province of South Africa. Australas. Plant Pathol. 2004, 33, 97–102. [Google Scholar] [CrossRef]
- Jiang, H.; Rao, Y.; Li, M.; Wang, Y. Antifungal activity of rapamycin on Botryosphaeria dothidea and its effect against Chinese hickory canker. Pest Manag. Sci. 2020, 77, 425–431. [Google Scholar] [CrossRef]
- Ma, Z.; Morgan, D.P.; Felts, D.; Michailides, T.J. Sensitivity of Botryosphaeria dothidea from California pistachio to tebuconazole. Crop Prot. 2002, 21, 829–835. [Google Scholar] [CrossRef]
- Froelich, M.H.; Schnabel, G. Investigation of fungi causing twig blight diseases on peach trees in South Carolina. Plant Dis. 2019, 103, 705–710. [Google Scholar] [CrossRef]
- Sosa, M.C.; Lutz, M.C.; Lódolo, X.V.; Basso, C.N. In vitro and in vivo activity of chemical fungicides and a biofungicide for the control of wood diseases caused by Botryosphaeriales fungi in apple and pear. Int. J. Pest Manag. 2022, 68, 328–338. [Google Scholar] [CrossRef]
- Pitt, W.M.; Sosnowski, M.R.; Huang, R.; Qiu, Y.; Steel, C.C.; Savocchia, S. Evaluation of fungicides for the management of Botryosphaeria canker of grapevines. Plant Dis. 2012, 96, 1303–1308. [Google Scholar] [CrossRef] [PubMed]
- Song, Y.; Li, L.; Li, C.; Lu, Z.; Men, X.; Chen, F. Evaluating the sensitivity and efficacy of fungicides with different modes of action against Botryosphaeria dothidea. Plant Dis. 2018, 102, 1785–1793. [Google Scholar] [CrossRef] [PubMed]
- Olmo, D.; Gramaje, D.; Armengol, J. Evaluation of fungicides to protect pruning wounds from Botryosphaeriaceae species infections on almond trees. Phytopathol. Mediterr. 2017, 56, 77–86. [Google Scholar]
- Hou, Y.; Guo, Y.; Wang, L.; He, S.; Zheng, W.; Liu, S.; Xu, J. Impact of phenamacril on the growth and development of Fusarium pseudograminearum and control of crown rot of wheat. Plant Dis. 2023, 107, 3843–3850. [Google Scholar] [CrossRef]
- Lalancette, N.; Robison, D.M. Effect of fungicides, application timing, and canker removal on incidence and severity of constriction canker of peach. Plant Dis. 2002, 86, 721–728. [Google Scholar] [CrossRef]
- Liao, M.J.; Zhang, Z.H.; Xi, P.G.; Wu, Y.Z.; Zhang, H.L.; Jiang, Z.D. Incidence and control of litchi stem rot in Zengcheng. China Trop. Agric. 2021, 4, 30–34.69. [Google Scholar]
- Miller, S.T.; Sterle, D.; Minas, I.S.; Stewart, J.E. Exploring fungicides and sealants for management of Cytospora plurivora infections in western Colorado peach production systems. Crop Prot. 2021, 146, 105654. [Google Scholar] [CrossRef]
- Zhang, C.Q.; Xu, B.C. First report of canker on Chinese hickory (Carya cathayensis) caused by Botryosphaeria dothidea in China. Plant Dis. 2011, 95, 1319. [Google Scholar] [CrossRef]
- Murashige, T.; Skoog, F. A revised medium for rapid growth and bio assays with tobacco tissue cultures. Physiol. Plant. 1962, 15, 473–497. [Google Scholar] [CrossRef]
- Liu, J.; Zhang, L.Y.; Wang, H.Y.; Liu, N.; Lian, S.; Xu, X.M.; Li, B.H. The effect of temperature and moisture on colonization of apple fruit and branches by Botryosphaeria dothidea. Phytopathology 2022, 112, 1698–1709. [Google Scholar] [CrossRef] [PubMed]
- White, T.J.; Bruns, T.; Lee, S.; Taylor, J. Amplification and direct sequencing of fungal ribosomal RNA Genes for phylogenetics. PCR Protoc. 1990, 18, 315–322. [Google Scholar]
- Glass, N.L.; Donaldson, G.C. Development of primer sets designed for use with the PCR to amplify conserved genes from filamentous ascomycetes. Appl. Environ. Microbiol. 1995, 61, 1323–1330. [Google Scholar] [CrossRef] [PubMed]
- Alves, A.; Crous, P.; Correia, A.; Phillips, A. Morphological and molecular data reveal cryptic speciation in Lasiodiplodia theobromae. Fungal Divers. 2008, 28, 1–13. [Google Scholar]
- Yu, L.; Wang, L.F.; Zhao, J.R.; Xu, S.G.; Gao, D.; Zheng, J.F. First report of Botryosphaeria dothidea causing canker and dieback disease of Helwingia chinensis in China. Plant Dis. 2012, 96, 1821. [Google Scholar] [CrossRef]
- Al-Naemi, F.A.; Nishad, R.; Ahmed, T.A.; Radwan, O. First report of Thielaviopsis punctulata causing black scorch disease on date palm in qatar. Plant Dis. 2014, 98, 1437. [Google Scholar] [CrossRef]
- Tang, W.; Ding, Z.; Zhou, Z.Q.; Wang, Y.Z.; Guo, L.Y. Phylogenetic and pathogenic analyses show that the causal agent of apple ring rot in China is Botryosphaeria dothidea. Plant Dis. 2012, 96, 486–496. [Google Scholar] [CrossRef]
- Tamura, K.; Peterson, D.; Peterson, N.; Stecher, G.; Nei, M.; Kumar, S. MEGA5: Molecular evolutionary genetics analysis using maximum likelihood, evolutionary distance, and maximum parsimony methods. Mol. Biol. Evol. 2011, 28, 2731–2739. [Google Scholar] [CrossRef]
- Shi, J.; Sang, W.J.; Lu, Y.H.; Zhang, D.P.; Kong, F.; Shou, A.F.; Yang, M.M. Identification of tobacco anthracnose pathogen and its biological characteristics in Guangxi. Chin. Tob. Sci. 2023, 44, 70–78. [Google Scholar]
- Cui, L.; Yang, C.; Jin, M.; Wei, L.; Yang, L.; Zhou, J. Identification and biological characterization of a new pathogen that causes potato scab in Gansu Province, China. Microb. Pathog. 2021, 161, 105276. [Google Scholar] [CrossRef] [PubMed]
- Shi, D.Y.; Wei, B.F.; Li, H.P.; Zeng, J.Y.; Wang, H.L.; Li, Y.L. Evaluation on the control effect of four biological fungicides against verticillium wilt of Cotinus. For. Pest Dis. 2023, 42, 46–50. [Google Scholar]
- European and Mediterranean Plant Protection Organization (EPPO). EPPO Standard PP 1/135(4): Efficacy Evaluation of Plant Protection Products—Phytotoxicity Assessment. EPPO Bull. 2014, 44, 265–273. [Google Scholar]

| Species | Isolate ID | ITS | tef1-α | β-Tubulin |
|---|---|---|---|---|
| SQ5 | STZ-1 = STZ3 = STZ2 | OR523573 | OR542956 | OR542955 |
| Neofusicoccum parvum | CBS 123650 | KX464182 | KX464708 | KX464994 |
| Neofusicoccum parvum | CBS 145622 | MN611179 | MN623346 | MN623343 |
| Neofusicoccum parvum | CBS 145623 | MN611180 | MN623347 | MN623344 |
| Botryosphaeria parva * | CMW9077 | AY236939 | AY236884 | AY236913 |
| Botryosphaeria parva * | CMW9081 | AY236943 | AY236888 | AY236917 |
| Botryosphaeria ribis * | CMW7772 | AY236935 | AY236877 | AY236906 |
| Botryosphaeria ribis * | CMW7773 | AY236936 | AY236878 | AY236907 |
| Botryosphaeria lutea | KJ 93.52 = CMW992 = CMW992 | AF027745 | AY236894 | AY236923 |
| Botryosphaeria lutea | CMW9076 | AY236946 | AY236893 | AY236922 |
| Botryosphaeria dothidea * | CMW8000 | AY236949 | AY236898 | AY236927 |
| Botryosphaeria dothidea * | CMW7999 | AY236948 | AY236897 | AY236926 |
| Botryosphaeria dothidea | JZG1 | KU360149 | KU565872 | KU565871 |
| Botryosphaeria dothidea | JZB310203 | MN945382 | MT269886 | MT371073 |
| Botryosphaeria dothidea | JZB310200 | MN945379 | MT269883 | MT371070 |
| Tiarosporella graminis | CBS 118718 | KC769962 | KF531807 | KF531808 |
| Number | Medicament | Toxicity Regression Equation | R2 | EC50 (μg/mL) |
|---|---|---|---|---|
| 1 | 40% Thiabendazole | y = 0.9782x + 4.3588 | 0.9996 | 4.5237 |
| 2 | Azoxystrobin | y = 0.358x + 4.2849 | 0.7922 | 99.4288 |
| 3 | 30% Metalaxyl-M-metidaxyl | y = 2.1806x + 2.7381 | 0.9348 | 10.8964 |
| 4 | 43% Tebuconazole | y = 1.4269x + 7.369 | 0.9689 | 0.0219 |
| 5 | 20% Thiediazole copper | y = 1.9096x + 3.5989 | 0.9829 | 5.4164 |
| 6 | Lime sulfur | y = 0.2771x + 4.3538 | 0.5997 | 214.7880 |
| 7 | 20% Xinjunan acetate | y = 0.0316x + 6.0327 | 0.9376 | 0.0271 |
| 8 | 36%Kasugamycin-oxine-copper | y = 1.5122x + 4.0343 | 0.8071 | 4.3512 |
| 9 | 40% Difenoconazole | y = 0.8937x + 5.8912 | 0.9658 | 0.0954 |
| 10 | 6% kasugamycin | y = 1.8315x + 3.9717 | 0.9861 | 3.6433 |
| 11 | 70% Thiophanate-methyl | y = 0.8978x + 6.5902 | 0.9918 | 0.0169 |
| 12 | 47% Kasugamycin-copper oxychloride | y = 1.58x + 4.2467 | 0.9383 | 2.9976 |
| 13 | 27% Bromothalonil | y = 1.1286x + 4.0043 | 0.8658 | 7.6243 |
| 14 | 33.5% Oxine-copper | y = 0.3398x + 4.3141 | 0.9464 | 104.3615 |
| 15 | 25% Oligosaccharins-ethylicin | y = 0.9268x + 4.8564 | 0.9802 | 1.4286 |
| 16 | 30% Zincthiazole | y = 0.4042x + 4.534 | 0.9429 | 14.2200 |
| 17 | 80% Bordeaux mixture | y = 1.1139x + 4.9288 | 0.9561 | 1.1585 |
| Medicament | Concentration (μg/mL) | Morbidity (%) | Disease Index | Average Efficacy (%) | Security |
|---|---|---|---|---|---|
| 43% Tebuconazole | 0.5 | 50.74 ± 5.23 c | 11 | 35.29 | Lower toxicity |
| 20% Xinjunan acetate | 2 | 57.55 ± 6.05 bc | 15 | 11.76 | Lower toxicity |
| 40% Difenoconazole | 4.5 | 70.00 ± 5.97 ab | 13 | 23.53 | Lower toxicity |
| 70% Thiophanate-methyl | 3.3 | 73.06 ± 1.06 a | 16 | 5.82 | Lower toxicity |
| Water (CK) | \ | 79.20 ± 1.49 a | 17 | \ | Innocuity |
| Fungicide | Manufacturer | Concentration (mg/L) |
|---|---|---|
| 43% Tebuconazole | Bayer CropScience China Co., Ltd., Beijing, China | 0.50 |
| 20% Xinjunan acetate | Hebei Shenhua Pharmaceutical Co., Ltd., Shijiazhuang, China | 2.00 |
| 40% Difenoconazole | Shanghai Hulian Biopharmaceutical (Xiayi) Co., Ltd., Shanghai, China | 4.50 |
| 70% Thiophanate-methyl | Xi’an Dingsheng Biochemical Co., Ltd., Xi’an, China | 0.63 |
| Water | \ | \ |
Disclaimer/Publisher’s Note: The statements, opinions and data contained in all publications are solely those of the individual author(s) and contributor(s) and not of MDPI and/or the editor(s). MDPI and/or the editor(s) disclaim responsibility for any injury to people or property resulting from any ideas, methods, instructions or products referred to in the content. |
© 2025 by the authors. Licensee MDPI, Basel, Switzerland. This article is an open access article distributed under the terms and conditions of the Creative Commons Attribution (CC BY) license (https://creativecommons.org/licenses/by/4.0/).
Share and Cite
Feng, J.; Yuan, Q.; Chen, X.; Fang, L.; Zhang, T.; Liu, Z.; Wang, Y.; Geng, X.; Cai, Q.; Li, Z. Identification and Chemical Control of Stem Canker Pathogen of Idesia polycarpa. Plants 2025, 14, 1393. https://doi.org/10.3390/plants14091393
Feng J, Yuan Q, Chen X, Fang L, Zhang T, Liu Z, Wang Y, Geng X, Cai Q, Li Z. Identification and Chemical Control of Stem Canker Pathogen of Idesia polycarpa. Plants. 2025; 14(9):1393. https://doi.org/10.3390/plants14091393
Chicago/Turabian StyleFeng, Jian, Qiupeng Yuan, Xuzhong Chen, Lisha Fang, Tao Zhang, Zhen Liu, Yanmei Wang, Xiaodong Geng, Qifei Cai, and Zhi Li. 2025. "Identification and Chemical Control of Stem Canker Pathogen of Idesia polycarpa" Plants 14, no. 9: 1393. https://doi.org/10.3390/plants14091393
APA StyleFeng, J., Yuan, Q., Chen, X., Fang, L., Zhang, T., Liu, Z., Wang, Y., Geng, X., Cai, Q., & Li, Z. (2025). Identification and Chemical Control of Stem Canker Pathogen of Idesia polycarpa. Plants, 14(9), 1393. https://doi.org/10.3390/plants14091393

